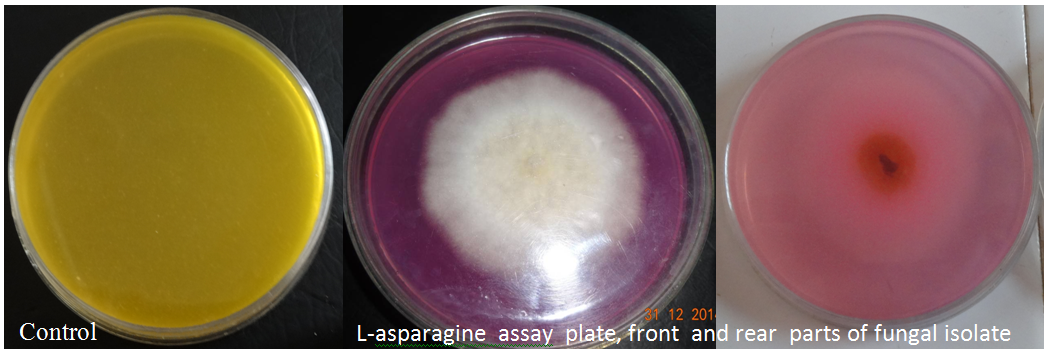

Int J Pharm Pharm Sci, Vol 8, Issue 1, 281-283Original Article
ISOLATION, SCREENING AND CHARACTERIZATION OF L-ASPARAGINASE PRODUCING FUNGI FROM MEDICINAL PLANTS
RAM KUMAR, VIJAY KUMAR SEDOLKAR, A. G TRIVENI, MENDEM SURESH KUMAR, CHANNAPPA T. SHIVANNAVAR, SUBHASCHANDRA M. GADDAD*
Department of Post Graduate Studies and Research in Microbiology, Gulbarga University, Kalaburagi, Karnataka 585106, India
Email: smgaddad@gmail.com
Received: 03 Sep 2015 Revised and Accepted: 25 Nov 2015
ABSTRACT
Objective:To isolate and characterize of L-asparaginase producing fungi from medicinal plants.
Methods: Fungal strains were isolated on standard media, characterized and were screened for their ability to produce L-asparginase, used in the treatment of certain types of cancers, using modified Czapek-Dox medium supplemented with L-asparagine.
Results: A total of 10 fungal isolates were obtained from 3 plant leaf samples and two isolates exhibited significant L-aspargniase production. Fusarium sp. (SMGR-F1) isolated from the papaya leaves showed the maximum activity. The organism was grown under submerged fermentation conditions at 30 °C produced 111.07±1.53 IU/ml of L-asparaginase at 120 h.
Conclusion: L-asparaginase is being effectively used for the treatment of acute lymphoblastic leukemia and tumor cells. Fusarium sp. was isolated from the papaya plant leaves showing significant L-asparaginase activity and thus can be further exploited for the commercial production of L-asparaginase.
Keywords: L-asparaginase, Fusarium sp. Papaya leaves, Submerged fermentation.
© 2016 The Authors. Published by Innovare Academic Sciences Pvt Ltd. This is an open access article under the CC BY license (http://creativecommons.org/licenses/by/4.0/)
INTRODUCTION
L -asparaginase [E. C 3.5.1.1] is a tetrameric protein that hydrolyzes free L-asparagine to aspartic acid and ammonia [1]. Under physiological conditions, the hydrolytic reaction is mostly irreversible [2]. L-asparaginases are among the largest group of therapeutic enzymes as they account for about 40% of the total worldwide sale of antileukemic and anti-lymphoma agents [3]. Apart from this, it is also used as a food processing agent as it reduces the level of acrylamide formation during the manufacture of starchy food products [4]. L-asparaginase is predominantly found in many organisms, bacteria, plants, fungi, actinomycetes, and serum of certain rodents. Compared to animal and plant enzymes, microbial sources are preferred as they can be produced economically using cheap substrates, can be easily optimized, genetically modified to produce high yield and further they can be extracted and purified. Extended advanced research focuses on eukaryotic fungal L-asparaginase since they have reduced side effects compared to bacterial L-asparaginases [5]. Molds of the genera Fusarium, Penicillium and Aspergillus, have been reported to secrete L-asparaginase having anti-lymphoma activity [6]. L-asparaginases of E. coli and Erwinia chrysanthemi have emerged as potent chemotherapeutic agents during the last 40 y, however they are associated with many side effects such as vomiting, leucopenia, fever, skin rash, nausea, thrombo-embolysis, difficulty in breathing, hyperglycaemia, weight loss, decreased blood pressure, sweating, immunosuppression, loss of consciousness, acute pancreatitis and neurological seizures [7, 8]. In the present investigation, we are reporting the isolation of an efficient L-asparaginase producing fungus from papaya plants.
MATERIALS AND METHODS
Collection of plant sample
Leaves of certain medicinal plants like Papaya (Carica papaya), tulsi (Ocimum tenuiflorum) and neem (Azadirachta indica) were collected in sterile polythene bags from areas in and around Gulbarga University, Kalaburagi, Karnataka, India. These three plants are extensively growing naturally/cultivated and are well documented by the Department of Botany, Gulbarga University, Gulbarga.
Isolation of fungi
One gram of leaf sample was weighed, and surface sterilized twice with distilled water and alcohol [9, 10], then homogenized in 1 ml distilled water and serially diluted. Different dilutions were plated on to Sabouraud’s Dextrose Agar plates and incubated at 30 ̊ C for 120 h.
Screening for L-asparaginase production
The fungal isolates were subjected for rapid screening for L-asparaginase production by plate assay using Modified Czapek Dox medium pH 6.2, containing (w/v) 0.2% glucose, 1 % L-asparagine, 0.152% KH2PO4, 0.052 KCl, 0.052% MgSO4.7H2O, 0.003 % CuNO3. 3H2O, 0.005% ZnSO4.7H2O, 0.003% FeSO4.7H2O, 1.8 % agar, with 0.009% phenol red as indicator. Plates with the same medium supplemented with NaNO3 as nitrogen source instead of asparagine served as control. The plates point inoculated with the fungal isolates were incubated at 30 °C for 72 h. The isolates that showed pink zone around the colonies indicated L-asparaginase production and were selected for determination of enzyme activity [11].
Inoculum preparation
Spore suspension was prepared from 120 h old culture grown on modified Czapek-Dox agar medium slants by adding 10 ml of sterile distilled water containing 0.1 % of Tween-80. The spore suspension containing ~ 1x10⁷spores/ml was prepared and used as inoculum.
L-Asparaginase production by submerged fermentation
L-asparaginase production was carried out by submerged fermentation. A 250 ml Erlenmeyer flask containing 50 ml of sterilized medium was used for production. One ml of the inoculum was added to the medium. The flasks were placed in an incubating orbital shaker at 150 rpm at 30⁰C for 120 h. The fungal cell mass was separated by centrifugation at 10,000 rpm for 15 min at 4⁰C. The culture supernatant was used as crude enzyme source to determine the enzyme activity and protein assay.
L-asparaginase assay
L-asparaginase activity was measured following the method of Imada et. al.,[12], which is based on the determination of ammonia liberated from L-asparagine by the enzyme reaction using Nessler’s reagent. Reaction was started by adding 0.5 ml supernatant into 0.5 ml 0.4M L-asparagine and 0.5 ml 0.5M Tris [hydroxymethyl] aminomethane [Tris-HCL] buffer, pH 7.2 and incubated at 37 °C and continued for 30 min. The reaction was stopped by the addition of 0.5 ml of 1.5 M trichloroacetic acid [TCA]. The ammonia released in the supernatant was determined colorimetrically by adding 0.2 ml Nessler’s reagent into tubes containing 0.1 ml supernatant and 3.75 ml distilled water and incubated at room temperature for 10 min and the absorbance was read in a UV-visible spectrophotometer at 450 nm. One unit of L-asparaginase activity is defined as that amount of the enzyme which catalyses the formation of 1 µmol of ammonia per min under the conditions of the assay.
Estimation of protein
Protein content was determined by the method of Lowry et. al., [13] using BSA as the standard protein.
Characterization
The fungal isolates showing a positive reaction on plate assay were selected and re ground to obtain a pure culture on the medium as per Gulati et. al.,[11]. Cultures were identified by their morphological and cultural characteristics up to the genus level [14].
RESULTS AND DISCUSSION
A total of 10 fungal isolates obtained from different medicinal plants were screened for L-asparaginase production using CDA medium. Most of the fungal isolates were found to be positive for L-asparaginase production. Out of 10, 5 isolates produced L-asparaginase by plate assay showing pink colored zones around the colonies (fig.1). Further, these isolates were subjected for secondary screening for enzyme activity by Imada et. al., [12]. Among them, 2 isolates showed the higher activity of 87.6 (SMGR-F5) and 111.07±1.53 IU/ml (SMGR-F1) (table 1) and other fungal isolates showed lower enzyme activities. Sarquis et. al.,[5] reported that A. terrus produced 58 IU/ml L-asparaginase activity, Aspergillus sp. isolated from soil showed 70 IU/ml [15]. Yadav and Sarkar (2014) reported that F. oxysporum produced 182 IU/ml [16], with optimized various parameters using submerged fermentation. The results indicate that our isolate SMGR-F1 is producing a comparatively higher L-asparaginase activity, that too under preliminary screening.
The colony morphology and the lactophenol stained microscopic observation (fig.2) indicated that the isolate (SMGR-F1) belongs to the genus Fusarium. The L-asparaginase production by the present isolate indicated that the isolate is a potential isolate and can be further developed for the commercial production of L-asparaginase. Many soil fungal species have been reported producing L-asparaginase. Eg., Emericella nidulans from different soils of Tumkur University Campus, Karnataka, India [17], Aspergillus flavus (KUFS20) from the garden soil of Coimbatore, Tamil Nadu, India [18] and Pencilllin species from soil samples of Bangalore, Karnataka, India [19,20]. Hosamani et al. (2011) reported the screening of Fusarium equiseti from rhizosphere soil of various plants around Karnataka university campus, Dharwad, Karnataka and suggested that the presence of the fungus might be due to the presence of a natural source of amino acids in the root exudates of the plants in the rhizosphere soil.
Fig. 1: Qualitative assay for L-asparginase
Table 1: L-asparaginase activity in the culture supernatant of fungal isolate
Fungal isolate No. |
L-asparginase activity (IU/ml) |
SMGR-F1 |
111.07±1.53 |
SMGR-F2 |
31.36±0.45 |
SMGR-F3 |
10.34±0.43 |
SMGR-F4 |
7.41±0.14 |
SMGR-F5 |
87.4±0.82 |
Sample size =3, Each value is represented as means±SD (n=3)

Fig. 2: Microscopic observation of spores of fungal isolate SMGR-F1
CONCLUSION
Our study clearly shows that papaya leaf sample can be a rich source of L-asparaginase producing fungi when compared to other plants and indicates Fusarium sp. (SMGR-F1) isolated from the papaya leaves can be exploited as a potential source for large-scale production of L-asparaginase enzyme to cope up the needs of industrial application and the demand of the global market.
CONFLICT OF INTERESTS
Declared None
REFERENCES
- Verma N, Kumar K, Kaur G, Anand S. L-asparaginase: a promising chemotherapeutic agent. Crit Rev Biotechnol 2007;27:45-62.
- Siddaligeshwara KG, Lingappa K. Production and characterization of L-asparaginase A tumour inhibitor. Int J PharmTech Res 2011;3:314-9.
- Warangkar SC, Khobragade CN, Dawane BS, Bhosale RB. Effect of dihydropyridine deravatives on the kinetic parameter of E. caratovora L-asparaginase. Int J Biotechnol Appl 2009;1:5-13.
- Tareke E, Rydberg P, Karlsson P, Eriksson S, Tornqvist M. Analysis of acrylamide, a carcinogen formed in heated foodstuffs. J Agric Food Chem 2002;50:4998–5006.
- Sarquis MI, Oliveira EM, Santos AS, Costa GL. Production of L-asparaginase by filamentous fungi. Mem Inst Oswaldo Cruz 2004;99:489-92.
- Lapmak K, Lumyong S, Thongkuntha S, Wongputtisin P, Sarsud U. L-asparaginase production by Biopolaris sp. BR 438 isolated from brown rice in Thailand. Chiang Mai J Sci 2010;37:160-4.
- Rossi F, Incorvaia C, Mauro M. Hypersensitivity reactions to antineoplastic chemotherapeutic agents. Recenti Prog Med 2004;95:476-81.
- Ramya LN, Doble M, Rekha VP, Pulicherla KK. L-asparaginase as potent anti-leukemic agent and its significance of having reduced glutaminase side activity for the better treatment of acute lymphoblastic leukemia. Appl Biochem Biotechnol 2012;167:2144-59.
- Hyde KD, Soytong K. Understanding microfungal diversity-a critique. Cryptogam Mycol 2007;28:281-9.
- Hyde KD, Soytong K. The fungal endophyte dilemma. Fungal Diversity 2008;33:163-73.
- Gulati R, Saxena RK, Gupta R. A rapid plate assay for screening L-asparaginase producing micro-organisms. Lett Appl Microbiol 1997;24:23-6.
- Imada A, Igarasi S, Nakahama K, Isono M. Asparaginase and glutaminase activities of micro-organisms. J Gen Microbiol 1973;76:85-99.
- Lowry OH, Rosebrough NJ, Farr AL, Randall RJ. Protein measurement with the Folin phenol reagent. J Biol Chem 1951;193:265-75.
- Aneja KR. Experiments in microbiology, plant pathology and biotechnology, New Age International (p). Ltd., Publishers. 4th edition. New Delhi; 2003.
- Soniyamby Ambi Rani, Lalita S, Praveesh Bahuleyan Vasantha. Isolation and screening of l-asparaginase producing fungi from soil samples. Int J Pharm Pharm Sci 2012:5:426-7.
- Niharika Yadav, Supriya Sarkar. Production of L-Asparaginase by Fusarium oxysporum using submerged fermentation”. Int J Pharm Sci Invent 2014;3:32-40.
- Jayaramu M, Hemalatha NB, Rajeshwari CP, Siddalingeshwara KG, Mohsin SM. A novel approach for detection, confirmation, and optimization of L-asparaginase from Emericella nidulans. Curr Pharm Res 2010;1:20-4.
- Rani SA, Lalitha S, Praveesh BV. In vitro antioxidant and anticancer activity of L-asparaginase from Aspergillus flavus (KUFS20). Asian J Pharm Clin Res 2011;4:174-7.
- Mushtaq MS, Siddalingeshwara KG, Karthic J, Sunil DPLNSN, Naveen M, Prathiba KS. Rapid screening and confirmation of L-asparaginase from Penicillium sp. Int J Res Pharmacol Pharm 2012;1:147-50.
- Hosamani R, Kaliwal BB. Isolation, molecular identification and optimization of fermentation parameters for the production of L-asparaginase, an anticancer agent by Fusarium equiseti. Int J Microbiol Res 2011;3:108-19.